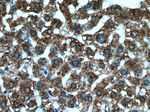
CYTL1 Antibody in Immunohistochemistry (Paraffin) (IHC (P))
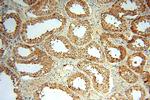
CYTL1 Antibody in Immunohistochemistry (Paraffin) (IHC (P))

Search
Proteintech
CYTL1 Polyclonal Antibody
{{$productOrderCtrl.translations['antibody.pdp.commerceCard.promotion.promotions']}}
{{$productOrderCtrl.translations['antibody.pdp.commerceCard.promotion.viewpromo']}}
{{$productOrderCtrl.translations['antibody.pdp.commerceCard.promotion.promocode']}}: {{promo.promoCode}} {{promo.promoTitle}} {{promo.promoDescription}}. {{$productOrderCtrl.translations['antibody.pdp.commerceCard.promotion.learnmore']}}
产品信息
15856-1-AP
种属反应
宿主/亚型
分类
类型
抗原
偶联物
形式
浓度
规格
纯化类型
保存液
内含物
保存条件
运输条件
产品详细信息
Immunogen sequence: MRTPGPLPV LLLLLAGAPA ARPTPPTCYS RMRALSQEIT RDFNLLQVSE PSEPCVRYLP RLYLDIHNYC VLDKLRDFVA SPPCWKVAQV DSLKDKARKL YTIMNSFCRR DLVFLLDDCN ALEYPIPVTT VLPDRQR (1-136 aa encoded by BC031391)
靶标信息
C17 is a cytokine-like protein specifically expressed in bone marrow and cord blood mononuclear cells that bear the CD34 surface marker (Liu et al., 2000 ).
仅用于科研。不用于诊断过程。未经明确授权不得转售。
生物信息学
蛋白别名: cytokine like 1; Cytokine-like protein 1; cytokine-like protein C17; NB4 apoptosis related protein; Protein C17
基因别名: 4930443F05Rik; 4Cytl1; C17; C4orf4; Cyt1; CYTL1; Gm147; RGD1561846; UNQ1942/PRO4425
UniProt ID: (Human) Q9NRR1
Entrez Gene ID: (Human) 54360, (Mouse) 231162, (Rat) 498392